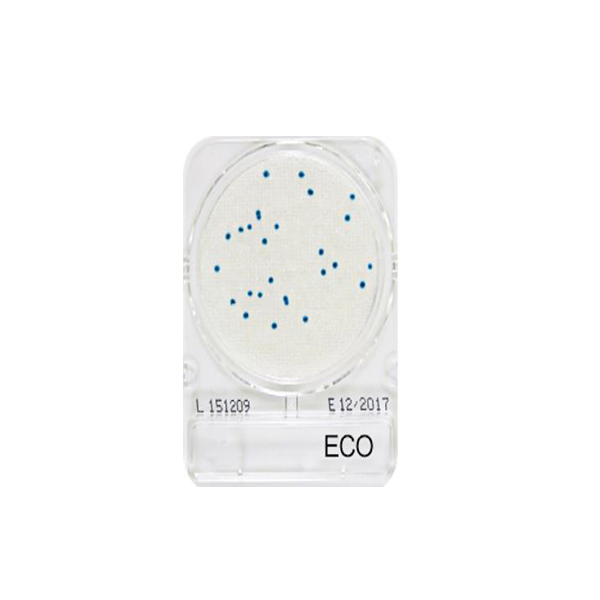

微生物快篩測試組_大腸桿菌 Compact Dry ECO
微生物快篩測試組_大腸桿菌 Compact Dry ECO
- 用途 : 檢驗大腸桿菌數
- 測試步驟 :
1. 將樣品滴入測試片。(必要時稀釋)
2. 以35±2℃進行培養24±2hr,取出測試片後判讀。
2. 以35±2℃進行培養24±2hr,取出測試片後判讀。
- 結果判讀 : 呈現藍~淡藍色者
- 保存條件 : 置於避光陰涼乾燥處,常溫保存勿超過30℃
- 適用產業 : 飲用水、化妝品、食品等產業
我要購買
我要兌換
- 用途 : 檢驗大腸桿菌數
- 測試步驟 :
1. 將樣品滴入測試片。(必要時稀釋)
2. 以35±2℃進行培養24±2hr,取出測試片後判讀。
2. 以35±2℃進行培養24±2hr,取出測試片後判讀。
- 結果判讀 : 呈現藍~淡藍色者
- 保存條件 : 置於避光陰涼乾燥處,常溫保存勿超過30℃
- 適用產業 : 飲用水、化妝品、食品等產業
產品說明
產品特色
- 專有薄膜材質,樣品自動平均分散。
- 乾式培養基,可放常溫保存。
- 特殊呈色基質,易於判讀。
- 日本製造,符合三大國際認證,品質穩定。
配件
- 快檢培養基(10包 共40片入)